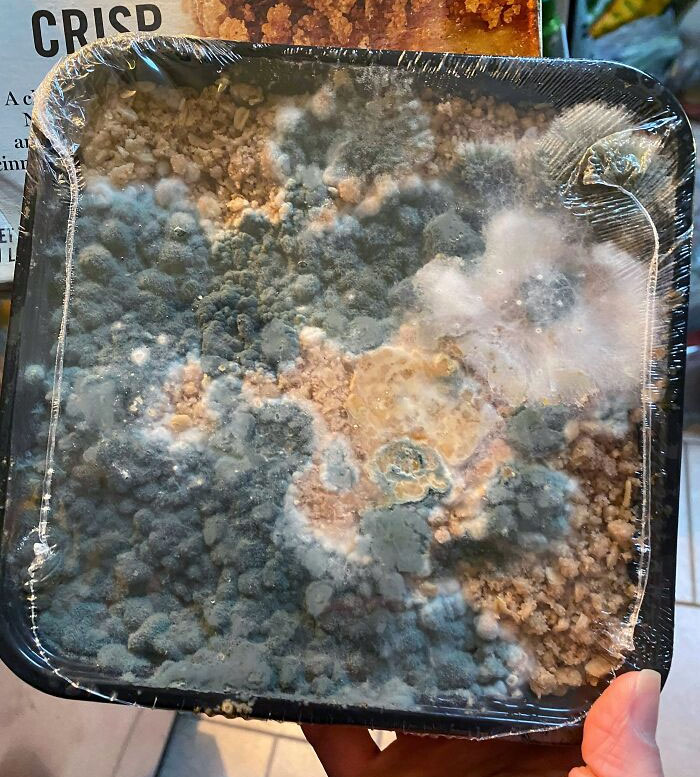

You wake up disoriented and realize your phone is dead. It’s 10am and you were supposed to be at work an hour ago, but your alarm clock is trapped in your phone that desperately needs to be charged. You bolt out the door as fast as you can only to see that your car has a flat tire. You need to call your boss, but your phone is still dead and you can’t even call a taxi without it. And when it seems like things can’t get any worse, you rush back up to your apartment to find that you’ve locked yourself out.
Did that paragraph stress you out? Sorry, take some deep breaths. It’s not your reality! But we all know that feeling of having a comically bad day. It’s like a storm cloud is hovering over us that we just can’t seem to shake because when it rains, it pours. After the fact, these terrible days often turn into funny anecdotes we can share with friends, once the relief of the day being over has set in. So to laugh along with (okay, and a little bit at) some people who have shared their worst fails and bad days online, we’ve gathered some photos of these horrible experiences down below for you.
Listen beautiful relax classics on our Youtube channel.
So sit back, relax, and be thankful that your day is not going as terribly as the days featured in these pics. Then if you’d like to check out even more hilarious fails that have been featured on Bored Panda, you can find our last articles on the same topic here and here.
#1 Aaaaaaaaaa
Image credits: ThisDudeHasTheLooooooooooooooooooooooooooooooooooongestUsername
Bad days are unfortunately something that we all have to live with. They can be caused by a multitude of reasons, including making a mistake that has rippling effects, losing something like our job or an important possession, being broken up with, having a fight with a loved one, getting injured or having a massively embarrassing moment. This list features the bad days that don’t have life-altering effects but that do make for a great story later down the line. From mildly annoying inconveniences to injuries that resulted in going to the hospital, on this list, you’ll find some of the funniest examples of bad luck people have ever experienced.
These photos got me wondering though, if some of us are genuinely more lucky than others or if we all have the same amount of good days and bad days. Perception is a factor in whether we consider a day to be positive or negative, of course, but when it comes to things that are actually out of our control, are some of us just unlucky?
#2 Cat Didn’t Eat For 3 Days, Went To The Vet Where They Did An Ultrasound Only To Find A Belly Full Of The Neighbor’s Cat’s Food
Image credits: Mysticstorms
#3 My Dog Had A 5k Surgery After Eating A Rock. I Decided To Display It Accordingly
Image credits: spirurulina
Richard Wiseman, a psychology professor at the University of Hartfordshire in the United Kingdom, studies the importance that luck plays in our lives. He began by looking at the difference between people who considered themselves lucky and those who identified as unlucky, and he found that the ‘lucky’ individuals were much more likely to be extroverted. They smiled twice as often and exercised more eye contact than the unlucky people as well. Wiseman believes that their sociability helps them end up in lucky situations because they meet more people, connect well with others and have an easier time maintaining relationships.
When it comes to the unlucky people, they were much more likely to be neurotic. Anxiety can help us focus on a task, but it can also allow us to put up blinders to other opportunities and miss what is going on around us. Unlucky people can be so busy worrying about one thing that they are oblivious to other opportunities passing by or miss details that could have helped them become ‘luckier’. Lucky people also tend to be more open minded and willing to put themselves out there when meeting new people and trying new experiences.
#4 Doing My Will. Needed Some Info From My Brother. Messaged Him To Ask His Address And Job Title. Failed To Remember Today Was His Birthday
Image credits: jessbowie
#5 So Costco Apparently Doesn’t Re-Take Membership Card Photos If You Sneeze
Image credits: BabyJesusAnalingus
#6 What If I Decide To Let My White Dog Out After I Mow My Lawn?
Image credits: sunshinyanny
Another interesting observation Wiseman made about lucky people is that they were simply more observant than unlucky individuals. He conducted one experiment where he gave participants a newspaper and asked them to count the number of photographs in it. Unlucky people took about 2 minutes to complete the exercise, but most of the lucky people only took seconds.
Listen beautiful relax classics on our Youtube channel.
That is because on the second page, there was a message that read: “Stop counting. There are 43 photographs in this newspaper.” The unlucky people often did not catch the message and continued to count the images because they were too focused to notice anything else. With these ‘unlucky blinders’ on, who knows what else these people were missing out on in their everyday lives?
#7 He Wanted To See What Was In That Hole. Guess What It Was
Image credits: AcidicKite
#8 Just Had Satan’s Moustache Crawl Across My Face When I Was Trying To Go To Sleep. My Skin Is Crawling
Image credits: Meowlik
#9 Happened In Germany. Elderly People Really Should Take A Second Driving Test
Image credits: switchery
Unsurprisingly, Wiseman also determined that lucky people are more optimistic. They go through life with higher expectations and even when something goes wrong, they are more likely to look on the bright side. Unlucky people might not actually have very different experiences, but they are more likely to dwell on the negatives.
Positive people might not necessarily attract good luck, but if they believe they have good luck, they are not going to be phased by a bad day here and there. They can shrug it off, upload a funny photo online, and go about their day. Of course, there are always extreme circumstances where a bad day is completely out of our control or societal issues prevent certain people from even having a chance at ‘good luck’, but we can’t deny that keeping a positive attitude is always preferable.
#10 Went To A New Barber. Asked For My Part To Be Cut In. She Mowed A 1/2” Stripe Out Of My Head
Image credits: Seandouglasmcardle
#11 I Guess They Won’t Be Driving Anywhere Anytime Soon, Seen Outside My Son’s Flat
Image credits: scorchednickel
#12 Don’t Want To Lose That Bikini Top
Image credits: youneverknowwhatyouregoingtoget
Wiseman is also an expert in helping people break their bad luck streaks and turn their luck around by enrolling in “luck school”. After one month of classes, 80% of Wiseman’s students reported feeling happier, more satisfied with their lives, and yes, luckier. The basic methods luck school students employed were keeping an open mind, being more observant, searching for the positive side in every situation, and going out of their way to break up their routines. So if you’re feeling unlucky the next time you have a bad day (a regular bad day, not a life-altering one!), don’t fall down into the dumps. If nothing else, you can remember that sharing a funny photo of your bad day online can help others smile, and that’s a bright side to your situation right there.
#13 My Dog Ate All Of My Games Yesterday While I Was Gone. Including My Copy Of Doom Signed By The Entire Development Team
Image credits: freddytylerpaul
#14 My Neighbor “Allegedly” Refused To Pay The Guy Who Cleared His Back Yard. He’ll Be Coming Home To This Gift Left In His Driveway
Image credits: CalbertCorpse
#15 Came Home For A Week To Help My Parents Out With Some Yard Work. Turns Out, I Don’t Know What Poison Ivy Looks Like
Image credits: BEARDBAR
If you’re having a bad day, and you’re looking for something to turn that frown upside down, there are plenty of ways to go about it. Getting in touch with nature, for example, can be an excellent way to boost your spirits. Some fresh air and sunshine, a peaceful hike, some yoga in a park, swimming in a lake, or even just going for a walk through a park near your home can be easy ways to unwind. Leave your phone at home or turn it on airplane mode and allow yourself to put aside the stresses of your day, your job, or whatever is giving you bad energy. And if you need to listen to music to drown out focusing on the bad day at hand, I highly recommend blasting some of your favorite bops.
#16 There Was An Attempt To Shoot Some Sweet Archery Video
Image credits: TheTim
#17 Found This Note On My Car After Work
Image credits: showmeurkittys
#18 My Boss Gave Me A Coffee
Image credits: TheMeadow
It can also be helpful to release all of your bad day energy onto paper or to a friend or loved one. Maybe you need to call your best friend, rant about the day, and move on. Bottling up our emotions is never a good thing, and releasing them can feel like a huge weight off your chest. Journaling is also an excellent way to decompress. I find that when I feel dramatic and like my world is spiraling out of control, putting my thoughts and feelings onto paper is very grounding. I realize how far out of proportion I was blowing up a situation in my head, and I can take time to express gratitude for all of the things that are going well. My life is not a tragedy, regardless of how hard my brain tries to convince me of that sometimes, so I feel much better when I take time to acknowledge the facts of a situation.
#19 Packed My Gym Bag Early This Morning In The Dark And Didn’t Want To Wake My Wife. Only Discovered My Choice On My Way To Shower In A Busy Men’s Locker Room
Image credits: buckeyespud
#20 Just A Snake Crawling Out Of My Wife’s Car At Customs During A Random Check
Image credits: 83Eighrythree
#21 My Dad Says “Google Is Doing This Stupid Thing Where It Blurs The Top Left Part Of The Results. Facebook Is Doing It Too Actually.” He Melted The Top Left Corner Of His Screen
Image credits: unidentifies
Sometimes a bad day can be remedied by treating yourself. Do something that you absolutely love, whether it’s watching your favorite guilty pleasure movie, cooking up your favorite comfort food meal, or grabbing ice cream from the shop that you always think about going into when you pass by. The little things can go a long way sometimes, so if buying yourself some flowers at the market or spending the evening painting your nails and taking a bath will put you in a better mood, I fully support it. We don’t all have the time to practice self-care every single day, but especially when we are more stressed than usual, we have to prioritize finding small ways to squeeze in moments of joy.
#22 New Hobby = New Broken Bones. 30 Seconds After Putting On Roller Blades Resulted In 2 Broken Wrists
Image credits: TamingFire
#23 Glad I Didn’t Decide To Sit In My Car This Morning And Defrost It
Image credits: NicholasStevenPhoto
#24 Got A Measuring Tape Without Measurements
Image credits: Qazpaz_G
Another great way to turn around a bad day is to find something that will make you laugh, or at least smile. Call up your funniest friend, watch your favorite comedy film, go see some stand-up, or scroll through your favorite funny articles on Bored Panda. It can be easy to go the whole day feeling stressed, angry or disappointed when you’re having a bad day, but not everything has to be colored by the failures of the day. Make sure you smile a little bit, and don’t be too hard on yourself. You deserve to enjoy some moments of every single day, even if you are in the hospital with two broken wrists from a roller-blading accident…
#25 Arrived To My Bathroom To Find A Friend Doing Some Exploration
Image credits: bensongrylls
#26 The Roof In My Apartment Collapsed Due To Rain, But The Latex Paint Caught The Drywall
Image credits: CadeVision
#27 My Instrument After A Flight. Thanks Southwest
Image credits: Yakabus
We hope these fails and unfortunate examples of bad days are bringing a smile to your face. Even though they were upsetting at the time, I’m glad that these individuals were able to laugh them off later and share their pain online. Remember that we all experience bad luck and bad days at times, so if you need to feel less alone, you can always consult this list and be glad you’re day was not this bad. Keep upvoting the pics that you feel the most sympathy for, and then let us know in the comments what your worst ‘comically bad day’ was. I wonder if any of you pandas have bad day stories that can top all of the pics on this list!
#28 Woke Up This Morning To My Light Full Of Water. Our Apartment Is Brand New
Image credits: euphoricbirthdaycake
#29 Waited All Summer To Cut Open This Watermelon I Grew In My Yard
Image credits: aweinschenker
#30 Anybody Know What It Means When This Light Comes On?
Image credits: ChiefNitro
#31 The Water At My Aunt’s Work In, You Guessed It, Florida
Image credits: Cultural_Necessary
#32 My Graduation Photo
Image credits: RamenNoodles851
#33 Went To A Concert Last Night. This Was My View For 3.5 Hours
Image credits: gippersmom
#34 So I Ordered McDonald’s Via Doordash And Found This In The Bag. Not Only Did The Doordash Driver Get My Order Wrong, But I Think He Messed Up Some Poor Dude’s Plans
Image credits: Xagreuss
#35 First Overseas Flight In 9 Years! Paid Extra For A Window Seat So I Can See Everything
Image credits: AWildAnonHasAppeared
#36 This Is Fine
Image credits: WhileFalseRepeat
#37 I Absolutely Hate My Life. The Third One Also Just Fell On The Pile
Image credits: Invicti8660
#38 My Daughter Might Be A Bit Accident-Prone
Image credits: poopsmitherson
#39 Got Home From Work, Ready To Have Some Blueberries And Wine. And Then The Bag Broke
Image credits: thePonks
#40 Pro-Tip: When Transporting Paint Make Sure It Is Properly Secured. Especially If You Are Driving A Maserati
Image credits: RAA
#41 When Your Cable Guy Drills A Hole In The Side Of Your House, Into A Closet, Through A Guitar Case, And Right Through Your Martin HD-28V
Image credits: Cumberland Guitars
#42 So My Friend Emailed Her Professor Today And This Happened
Image credits: Dua_Flip
#43 That Time I Broke One Of The Screws In My Back
Image credits: cubs1917
#44 My Friend Just Broke My Several Million Years Old Piece Of Amber That I Got While I Was Living In Australia
Image credits: The-Communist-Cat
#45 My Customer’s Husband Decided To Preheat The Oven For Snacks And Had No Idea That His Wife Had Left The Laptop In The Oven
She did this to prevent the laptop from being stolen while they were on vacation.
Image credits: LosMyUit_asb
#46 Doesn’t Fit
Image credits: vanilla_lychee
#47 I Found My Lunch (In A Tote On My Desk), From Two Years Ago. I Didn’t Open It For Fear That It Could Trigger Another Pandemic
Image credits: xaxwyf
#48 Can’t Email My Township Unless You Can See Color, Which I Can’t
Image credits: Drajl19
#49 There Was An Attempt To Send A Text
Image credits: cooooorn
#50 Girlfriend Told Me The Hot Water Isn’t Working So I Went To The Basement To Investigate
Image credits: LargeThighMeat
#51 Came Home From The Vacation To This. Hose Broke And Was Spraying Water For Days In Subfreezing Temperature
Image credits: KingOfKrackers
#52 Went To Show My Bunny The Forest. Sounded Better In My Head
Image credits: lil_sakamadaV2
#53 No Passenger Was Harmed In The Making Of This Error
Image credits: mattjstyles
#54 Happened Today In My Hometown
Image credits: KookyJosephSmith
#55 My Cat Knocked Over 2 Gallons Of Laundry Detergent Onto The Floor While I Was At Work (My Floor Is Not Blue… It’s White)
Image credits: Cadyus
#56 My Brother Tried To Dye His Brand New Nikes In Coffee And Forgot About Them For A Month
Image credits: kushtopherrobhisass
#57 After 16 Consecutive Hours Of Work, I Come Home To Find This
Image credits: pjffty3000
#58 “Honey, Have You Seen My Other Airpod?”
Image credits: GraTaylor
#59 Five Minutes After They Delivered My Table
Image credits: gilbertthefishx
#60 I Asked My Wife To Tidy Up My Neck With The Clippers…. Yes We Are Still Married
Image credits: LongjumpingWallaby8
#61 Customs Office Destroyed My Sculpture Someone Bought From Me Because They Wanted To Check If I Didn’t Hide Drugs Inside
Image credits: tadamig
#62 New Neighbors’ Truck… Every Night
Image credits: vuxnomica
#63 I Put A Hole In The Wall Because I Passed Out While Blowing My Nose
Image credits: youworry
#64 New Hyperloop Is Being Built In Novosibirsk, Russia
Image credits: r_lighter
#65 Just Spent The Last 3 Hours Cooking For Family Coming Over. Then They Brought Their Own Takeaway To Eat
Image credits: grey-clouds
#66 I Came By My Storage Unit To Pick Up Some Stuff Just To Find That Someone Cut My Lock Off And Placed Their Own
Image credits: Good_Is_Evil
#67 Slaved Over A Dinner Date, Got Stood Up
Image credits: navimc
#68 This Person Is Double Parked Into My Parking Spot And I Can’t Park My Vehicle Or I’ll Block Another Spot Next To Me
Image credits: techhausinc
#69 My Address Is 444 And This Is The Only Place In Town That Sells House Numbers
Image credits: thatyeetboi79
#70 Take The Day Off To Renew My Tag And It’s A Government Holiday?
Image credits: DangrRangr
#71 I Baked A Cake For My Work Colleagues For My Birthday And Nobody Took Any
Image credits: Marco3712
#72 This Watermelon That I Grew
Image credits: NeedlesMakeMeFaint
#73 Ordered Eight Extra Large Shirts; Received Eight 8XL Shirts
Image credits: ch0ch32
#74 This Literally Happens At This Exact Spot About Once A Month
This is what you get when you rent a truck and don’t read the height restriction
Image credits: TheJaphyRyder
#75 My Son Teased His Sister, And She Threw A Switch Controller At My Parent’s 75-Inch TV
Image credits: cravenight
#76 My Mother Destroyed My Computer Screen Because My Dogs Woke Her Up
Image credits: Radioaktivman999
#77 Let Someone Borrow My Truck, This Is How It Was Returned
Very dirty and random wire coming from the dash going to nothing, scarred up hood (sun fade was already there), before vs. after the bent exhaust, broken dash, and check engine light on.
Image credits: Dalejrfan5150
#78 Yup, That Is Me. The Idiot Stuck In A Silt Bed In A Ford F350 Tremor
Image credits: Jammminjay
#79 Friend Woke Up To See His Car Like This
Image credits: Snowbunny236
#80 She Has Separation Anxiety
Image credits: Aubu
#81 Shout Out To That Time I Was Reading Of Mice And Men For High School And My Copy Of The Book Had The Last Page Missing With The Back Cover Just Saying “Surprise”
Image credits: Thicc_Succ_Lord
#82 Crash In California
Image credits: happydolphin22
#83 This Fallen Tree In Amsterdam
Image credits: Redactie Amsterdam
#84 Can Someone Tell Me How It’s Possible My Shower Door Shattered While I Was Gone For 2 Hours?
Image credits: tcheeset
#85 Steering Wheel And Airbag Theft. Third One This Month. Has Anyone Else Seen A Rise In These Kinds Of Things?
Image credits: Ears_McGee629
#86 How My Sister Left Our Apartment After Moving Out
Image credits: Im_Rolo
#87 My Dad Said He Would Make Dinner Today And Grilled The Expensive Bullet Steak I Bought. This Is The Result
Image credits: eternityforum
#88 A Bullet Came Downwards Through My Sister’s Window After New Years
Image credits: AtomicEmerson
#89 This Is Why You Don’t Hire Contractors Who Secure Cabinets To Dry Wall Only, Thousands In Damage Last Night
Image credits: tommybres
#90 Finland’s Olympic Athlete Dormitory In Beijing
Image credits: PeasKhichra
#91 Wind Was A Little High In Colorado
Image credits: kbbn1
#92 When You Buy Three 6900 XTs For $3000 From Russia And Get Noodles And Newspapers
Image credits: Arcticyclone
#93 How My New Computer Just Got Delivered
Image credits: this_is_a_username78
#94 Bender Fender, Hit And Run. Long Beach, California
Image credits: EequalsMCsquirrels
#95 It Will Cost A Lot To Repair The Car
Image credits: 23skidoobbq
#96 The Ceiling Of My School Gym Just Collapsed
Image credits: Moofritte
#97 Bought A House In A Bidding War So Inspection Waived. Moving In I Dented The Wall And Made A Hole. This Was Behind The Hole
Image credits: Sserenitynoww
#98 Went To The Store To Pick Up A Candle For My Daughter’s Birthday, Guess How Old She’s Turning?
Image credits: wtfbananaboat
#99 A Week After Installing Our New Garage Door Opener Our Teenager Backs Into Both Garage Doors Completely Dislodging Them And Hitting A Support Beam
Image credits: BunBunChow
#100 My Backyard Burned Down While I Was Taking A Dump
Image credits: Zareldo
#101 Guys Help, My Finger Is Actually Stuck. What Do I Do?
Image credits: Icalleveryonestupid
#102 The Plane I’m In Is Super Foggy For Some Reason
Image credits: _ShaveTheWhales_
#103 Drove My 17-Year-Old Son To Visit My Childhood Home
Image credits: gjawhar
#104 The “Grilled Cheese Reuben” I Spent $15 On And Over An Hour Waiting For
Image credits: Educational_Let3723
#105 My Brother Forgot About This In The Fridge For Almost 2 Months
Image credits: MadameMegatron
#106 Left My Car Sitting At Work For A Little Over A Month. Went To Go Pick It Up Today And The Interior Is Covered In Mold. FML
Image credits: The_Uninspired_One
#107 Came Back To My College Apartment This Morning With My Roommates Having Done This
Image credits: thethinkernut
#108 I Attended My Sister-In-Law’s Ash Internment Yesterday, And They Brought Her Ashes To The Cemetery In A Sports Direct Bag
Image credits: zappapostrophe
#109 Alarm Fire In Salt Lake City. New Apartments Under Construction Burned Up And Took 12 Businesses With It Including A Porsche Dealership. 65 Firefighters Attended
No injuries. Still watering down the hotspots tonight
Image credits: chrisell
#110 Amazon Sent Me An Empty Bag, And The Delivery Picture Shows It Was Open
Image credits: ynnubyzzuf
#111 Guess Who Only Had Cash
Image credits: whirlpoohl
#112 Ordered (Boneless) Wings For The Big Game. Only Three Were Not Completely Raw. It Was $76 And DoorDash Refuses To Give Us A Refund
Image credits: CeeceeLarouex
#113 Been Listening To This Guy Weedwhack A City Lot All Day. Who Is Punishing This Man?
Image credits: TroubleHeliXX
#114 I Heard A Loud Pop Under My Desk Only To Find This
Image credits: Damonthepoof
#115 Made It Half Way Home Before I Bit Into One Of These Not-McDonald’s-Nuggets In The Car, In The Dark, And Almost Puked
Image credits: puffpuffpout
#116 Somebody Sank Their Water Ferrari And Just Left It
Image credits: Eu_Nao_Concordo
#117 Well I’m Permanently Half Blind Now. How Are You Guys Doing?
Image credits: BeastlyBucaroos
#118 My University Is Burning 20 Minutes Into New Year
Image credits: ArkhangelskAstrakhan
#119 Screw You Tesla
Image credits: jernej_mocnik
#120 Flipped And Abandoned G Wagen
Image credits: asonjones
#121 The Water At My Aunt’s Work In, You Guessed It, Florida
#122 I Put A Hole In The Wall Because I Passed Out While Blowing My Nose
#123 Came Back To My College Apartment This Morning With My Roommates Having Done This
Source: boredpanda.com